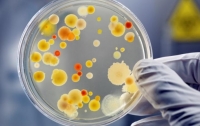
Каждый пятый ресторан в Украине работает с нарушениями, - Госпродпотребслужба

ВСЕ НОВОСТИ
-
 18:00 Экономика
18:00 Экономика
В столице все еще много людей посещают рестораны
-
17:51 Общество
17:51 Общество
Каждый пятый ресторан в Украине работает с нарушениями, - Госпродпотребслужба
-
 18:27 Киев
18:27 Киев
Проверки киевских ресторанов: почти в 100% проблемы с санитарией
-
20:07 Мир
В Кремле появился глава общепита
-
12:02 Мир
Российский общепит рискует остаться без алкоголя
-
 13:04 Общество
13:04 Общество
Арбузов поручил проверить безопасность украинского общепита
Чиновник уверен, что государство обязано обеспечить комфортные условия для отдыха граждан
-
 08:31 Общество
08:31 Общество
В Киеве активисты прикрыли «разливайку»
Общественники легально добились закрытия незаконной точки по продаже спиртного
-
 18:42 Общество
18:42 Общество
В Киеве оштрафуют на 10 тысяч первое кафе за курение
-
 09:00 Мир
09:00 Мир
McDonald’s сделал ставку на дешевые блюда и... резко увеличил прибыль
В 2013 году компания планирует потратить $3,2 млрд на открытие 1600 ресторанов
-
 10:29 Общество
10:29 Общество
Закон о запрете курения расколол общество больше, чем «языковой» закон
Украинцы и рестораторы пока не спешат выполнять нормы «антитабачного» документа
-
 12:20 Общество
12:20 Общество
Рестораны и кафе продолжают нарушать запрет на курение
Общественные активисты обещают проводить рейды и контролировать выполнение закона
-
 07:31 Общество
07:31 Общество
В Киеве некурящие будут спасать официантов и барменов
-
 12:40 Общество
12:40 Общество
Украинский общепит нанял охранников стеречь котлеты (ФОТО)
-
 08:40 Общество
08:40 Общество
Сегодня в Киеве установят «туалетный» рекорд
Горожане с общественными активистами построят самую длинную очередь в общественные удобства
-
 14:24 Общество
14:24 Общество
Как в Одессе шутят над общепитами (ФОТО)
Еда и продукты – чем не повод для шутки, решили одесситы и весь свой юмор направили на рестораны и магазины




